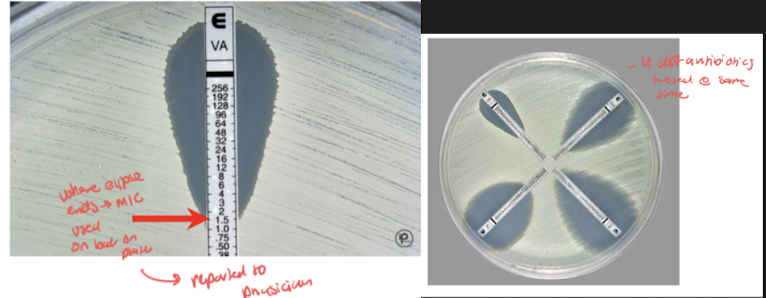

med microbio--MODULE 7. ANTIMICROBIAL AGENTS
1/55
There's no tags or description
Looks like no tags are added yet.
Name | Mastery | Learn | Test | Matching | Spaced |
|---|
No study sessions yet.
56 Terms
selective toxicity
a pharmacologic effect whose ability to destroy or inhibit the microbe without damaging the human host (desirable outcome when only functional on bacterial cells, not human cells)
*Not all antimicrobic agents do this
theraputic index (TI)
what would a good TI look like and mean
a measure of selective toxicity: ratio of max dose tolerated/min dose required
The higher the TI the better it is for the patient (high amt tolerated, low amt required to kill bac)
Every drug has consequence (benefit to risk ratio)
bactericidal and 3 examples
a functional effect capable of killing bacteria, kills microbe as its mech of action
Ex: vancomycin, daptomycin, penicillin
bacteriostatic and 3 examples
a functional effect capable of inhibiting growth/ reproduction of bacteria (starts when treatment starts) antimicrobic that inhibits multiplication/growth as its mech of action
Ex: clindamycin, tetracyclines, erythromycin, etc
An infection is when there is a presence and inc in numbers of bactera; stop rep means to infection→allows for immune response to function naturally and kill bacteria (helps overloaded immune response when large number of infectious bacteria)
Antibiotic (use in bacteria themselves)
substance produced by a microbe that has the capability to kill/inhibit other microbes; find niche and create agents to elim other competitors
3 sources of antimicrobial agents:
1. Chemical – chemical with antimicrobial action like heavy metals (silver)
Synthetic– commercially synthesized and marketed: allows for mass prod of antimicrobic agent, once the structure is known, it can be commercially prepared/synth
ex) insulin (big deal was finding the structure that works so we can mass prod)
Microbial– substance produced by a microbe
Antimicrobic spectrum (2 subcategory names)
the variety of microorganisms an antimicrobial agent can effectively inhibit or kill (broad or narrow)
Competitive inhibition
substrate and inhibitor compete for binding to same site on enzyme; halts process
Minimal inhibitory concentration (MIC)
lowest conc of antimicrobial agent capable of preventing growth of the microbe
Minimal bactericidal concentration (MBC)
lowest conc of antimicrobial agent capable of killing the microbe
Serum bactericidal level
and why caused in patient
det. treatment effectiveness in inhibiting/killing the bac isolate responsible for patient infection
*Occasionally used for complications in treatment due to resistance, allergic reactions, etc that limit antimicrobics available for use
susceptible (bacteria)
bacteria that’s growth (whether death or stasis of growth) is impacted by an antimicrobic agent
a critical aspect of clinical microbio is the determination of antimicrobial susceptibility of bacteria isolated from patients. This is the ultimate goal of what effects an antibiotic treatment will have on the patient (what works in vitro will more than likely work on patient)
Resistant (bacteria)
developed mechanism to resist antimicrobic action
Etest
establish antimicrobic density gradient in agar plate → det. MIC where growth ellipse intersects w scale on Etest strip
Antibiogram:
composite report of antimicrobial susceptibility profiles of bac isolates from w/in a community or locale
combination effect
and example of its implementation (with biofilm)
use more than a single antimicrobic as a treatment strategy, one works but not as fast or potent as needed, so add second; ex) 1 is effective against bacteria that forms biofilm so add 2 to teardown biofilm first that allows 1 to better work
indifference vs additive vs synergy vs antagonism effects of bacteria (w/ visual equations)
indifference= no additional benefit w combo compared to each one alone (no enhanced eradication. 1x (anti1) + 1x (anti2) = 1x effect. Doesn’t justify combo effect
additive= effect of one drug adds to effect of second drug; combo justified; 1x + 1x = 2x effect
synergy= combination produces enhanced effect beyond that of either drug alone; 1x + 1x > 2x effect (more than 2x effect→optimal)
antagonism= combination effect where one drug counteracts the effect of the other; 1x + 1x < 1x effect; less than 1x effect/drug by itself→ won’t make combo
narrow vs broad spectrum drugs (and example of each)
Narrow spectrum= effective specifically against one type of organism
ex) penicillin is more effective against gram pos than gram neg bac
spectrum=gram pos
Broad spectrum= effective against several types of organism
ex) tetracycline is equally effective against gram pos and gram neg
List the 3 groups of organisms that have yielded useful antibiotics.
one example of each
Molds:
Penicillin lead field of ID antibiotics and what pattern others began to search for
Alexander Fleming reported the existence of it in 1928 but was unable to purify for use as an antibiotic. Staphylococcus in region of penicillium colony were undergoing lysis (dying) by some unknown substance produced by the mold
Bacteria were not growing despite food being available; a measurable distance away from the penicillin colony
We copy nature bc microbes inform us how to prevent growth
Cephalosporium is a wheat fungus
Actinomycetes:
“Branching bacteria”
Streptomyces is a soil actinomycete: og source of streptomycin
Bacteria
Bacillus subtilis produces many antibiotics
Interference with essential metabolites as an antimicrobic mech of action
example (substrate and inhibitor)
antimicrobic disrupts critical metabolic pathway
Enzyme inhibition as an antimetabolic process:
Reaction w/out inhibitor: S + E → ES → E + P and E starts process again
Enzymes speed up reaction to allow for high enough rate for process to allow organism survival, by blocking, reaction does not occur fast enough
Reaction w/ inhibitor: S + E + I → EI + S (competitive inhibition)
Ex: PABA (substrate) and sulfa drugs (sulfonamides inhibitor) compete for binding to the same site on enzymes
Impairment of structural integrity as a antimicrobic mech of action
example
mechanism of action is binding to peptidoglycan thereby disrupting cell wall structure in bac pop that are replicating (primary a mech against gram pos bac)
ex) penicillin which binds to peptidoglycan and disrupts formation of cell wall by making holes
Inhibition of protein synthesis as antimicrobic mech of action
example of drug that binds to 30S reversibly and irreversibly, and 50S reversibly (2)
ribosome disruption/disrupts translation by binding to various points on ribosomal subunit (can be bacteriostatic or bactericidal dep on if reversible or not)
Work by:
Bind to 30S ribosomal subunit (reversible–tetracycline)
Irreversibly bind to 30S (aminoglycosides)
Bind to 50S ribosomal subunit (reversible–choramphenicol, erythromycin)
Interference of nucleic acid synthesis as an antimicrobic mech of action (3 general ways)
protein synthesis halted and polymerase disrupted
Gen mech:
Disrupt transcription (DNA→RNA)
Disrupt replication (DNA →DNA)
Break DNA molec
Disruption of the cell membrane as antimicrobic mech of action
example (2)
regulation of cell traffic disrupted
Processes:
Bind to phospholipids
Alter cell perm
Disrupt osmotic integrity (req high amt of moisture to survive)
ex) bacitracin, polymixin
what is optimal selective toxicity/TI
no damage of host while ability to destroy bac (TI= max dose tol by host / min dose req to kill)
narrow/broad spectrum of effectiveness, gram pos or gram neg targeted most commonly
narrow is effective against one type, broad is effective against several (gram pos have peptidoglycan in cell wall, gram neg don’t so this is often targeted in gram pos like with penicillin)
Bactericidal versus. Bacteristatic
kill outright or halt growth to allow for immune system to catch up
inhibition of essencial metabolites: drugs (1) and general mech
Sulfa drugs
Inhibition of critical pathways
impairment of cell wall integrity drugs (6) and general mech
Vancomycin, b-lactam drugs, “cillins”, cephalosporins, monobactams, carbapenems
Target peptidoglycan
inhibition of protein synthesis drugs (4) and mech
Tetracycline, aminoglycosides, chloramphenicol, erythromycin
Bind to ribosomal subunits reversibly or irreversibly
interference with nucleic acid synthesis drugs (3) and mech
Rifampin, quinolones, metronidazole
Prevent transcription/ DNA formation
disruption of cell membrane drugs (2) and mech
Bacitracin, polymyxin
disrupt/alter cell permeability
sulfa drugs:
inhibitor name that mimics substrate
general mech
broad or narrow spec
synthetic or natural antimic
selective tox/TI
mech of inhib
adv (2)/disav (3)
PABA (substrate) and sulfa drugs (sulfonamides inhibitor) compete for binding to the same site on enzymes *(inhibition of essential metabolites)
Folinic acid is the active form of folic acid (all cells need folic acid for growth bc needed for purine and pyrimidine formation)
Bacteria must synthesize their own folic acid from PABA but mammalian cells do not need to synthesize bc provided in diet (therefore high TI drug if inhibits pathway)
Sulanilamide (drug) looks structurally similar to PABA and thus compete at first step via competitive inhibition–halkts progression of path that uses purines to make DNA
Overwhelm env w/ antibiotic to inc winning out competition and elim bac
Since drug has been used for a long time, now antibiotic resistance
Summary:
Synthetic antimicrobial agent
Broad spectrum (gram pos and neg)
Selective toxicity (toxic for bac, not for mammalian cells)
Mechanism of inhib: block bacteria’s ability to produce a metabolite essential for life (DNA)
TI is high since humans use dietary folic acid and bac have to synth their own (high tolerance by host / low dose needed against bac)
Disadvantages:
Bacteriostatic instead of bactericidal (may take longer to red bac numbers since immune sys is needed)
Insoluble at acid pH (may precipitate in urine if used to treat UTI, which can lead to kidney damage)
Many resistant strains are present due to widespread use of sulfa drug
Advantages:
Readily absorbed into tissues
Crosses blood brain barrier to treat brain abscesses, which not many drugs do; kept present in hospital formularies
penicillin:
general mech
biochem structure of inhibitor
generally selects against ___
broad or narrow spec (variation dep on what)
bactericidal or static
selective tox/TI
mech of inhib
adv (1)/disav (2)
penicillin which binds to peptidoglycan (gram pos have a lot) and disrupts formation of cell wall by making holes (*impairment of cell wall integrity)
A characteristic epitomized by penicillin is presence of a beta-lactam ring in its structure that has anti bacterial properties
Problem is that some bac have evolved to produce an enzyme beta-lacamase that cleaves the beta lactam ring rendering the antimicrobic ineffective (evolved)
Ring used in other antimicrobic agents: cephalosporins, monobactams, carbapenems; if can cleave ring, bac will be resistant regardless of type of antimicrobic agent
Drug company response to beta-lactamase production by bac has been to make chemical mod to existing structures
Penicillin G is the initial penicillin
Subsequent changes have resulted in many diff types with similar structures (ampicillin, amoxicillin, methicillin, etc)
Other beta lactam antibiotic summary:
TI: high since effect on mammalian cells is nothing (no peptidoglycan in mammals)
Activity: disruption of cell wall is bactericidal
Spectrum: varies and is dependent on R group modifications (tweaking to combat resistance) to antibiotic structure
Generally, effects on gram pos>gram neg
Disadvantages:
Hyper sensitivity reactions– esp penicillin (can elicit all 4 types of hypersensitivity reactions so common)
Acts as hapten (bind to make more immunogenic), attaches to albumin, is antigenic, can cause immune probs
Microbe resistance
Many bac have acquired b-lacamase encoding plasmids that break open b-lactam rings that combat infectious bac
Advantages: very effective against bac with no b-lactamase
tetracycline:
source
TI
mech
static/cidal
spectrum
disav (3—where rez is mediated from, toxic where, inactivation how)/adv (2)
Source: (where we learned structure from) streptomyces (an actinomycete)
TI: low
Readily bind serum proteins in stomach that makes it become inactive or minimally active, therefore high doses are needed–this affects min dose req
Not easily excreted which affects max dose req
Activity:
Binds 30S ribosomal subunit in reversible manner (*inhibition of protein synthesis)
Inhibits rRNA attachment to mRNA codon
bacteristatic
Spectrum: broad
Disadv:
Plasma mediated resistance is common
Hepatoxic (liver damage) w/ continuous high doses
Inactivated by foods; pharm rec for take one hr before or 2 hr after meals to prevent binding to food and red absorption
Structure: 4 fused rings with 4 R groups for possible mods
Bind to small subunit which inhibits rRNA attachment to mRNA codon
tRNA can’t enter/bind and position self for translation so translation halts
rifampin:
source
mech
static/cidal
spectrum
disav (2)
Activity: bactericidal
Mech: bind RNA pol and prevent transcription (mRNA synth)
*interference w nucleic acid synth
Source: streptomyces
Spectrum: narrow–gram pos
Effective against m. tuberculosis
Disadv:
Resistance develops quickly
Liver toxicity
Usually used in combination with other drugs
Bacitracin:
source
cidal/static
TI
disav (1)/ adv (1--typical use)
Source: microbial (bacillus)
Activity: bactericidal
Spectrum: limited
Effective against gram pos (polymyxin is effective against gram neg)
TI: low
Mammalian cells affected as well as bac
Disadv: very toxic
Adv: effective and useful as topical ointments for superficial dermatologic infections
Triple antibiotic topical ointment with polymyxin, neomycin, bacitacin
Chloramphenicol:
source
mech
static/cidal
spectrum
TI
disadv (2) / adv (1)
Source: streptomyces
Activity: binds to 50S ribosomal subunit in a reversible manner – prevents peptidyl transfer and peptide bond formation
bacteriostatic
Spectrum: broad
Disadv:
Toxic effects at high doses (low TI)
Interferes with RBC development; can cause aplastic anemia
Adv:
Readily diffuses into cells and CNS – useful against CSF infection bc can cross blood brain barrier
Effective against serious brain abscesses
Gentamycin:
example (1/ general naming ends)
mech
static/cidal
source
disacv (3—toxic cond for 2 and ineff against what bac)
aminoglycoside (others all end in -mycin)
Source: streptomyces
Activity:
Bind 30S ribosomal subunit in an irreversible manner
Change shape of 30S, causing misreading mRNA codon (wrong AA added), terminating protein synth
bactericidal
Disadv:
Ototoxic (hearing), nephrotoxic (kidney nephron)
Ineffective against anaerobic bac
List and describe general mechanisms of bacterial resistance to antimicrobic action.
intrinsic vs aquired resistance
6 pathways to resistance
5 reasons for emergence of antimicrobic resistance
Characteristics of intrinsic (naturally coded and expressed by all or almost all strains of that particular bac species) and acquired resistance (changes in genome through mutation or horizontal gene acquisition that lead to changes in nature of proteins expressed; these changes may lead to alt in structural or functional features of bac, which may result in changes leading to resistance against antibiotics) →common pathways of resistance:
Enzymatic degradation or modification of the antimicrobic agent (add or modify enzyme or destroy it)
decrease uptake or accumulation of the antimicrobial agent
altered antimicrobial target (alter step and metabolic pathway so antibiotic doesn't have a place to come and act)
circumvention of the consequences of antimicrobial action
uncoupling of antimicrobial agent–target interactions and subsequent effects on bacterial metabolism
any combination of the above
Summary and examples:
Enzymatic degradation or modification of the antimicrobic agent: Innate production of enzymes that inactivate the drug
decreased uptake or accumulation of antimicrobial agent: Extrusion of the drug by chromosomally encoded active exporters
altered antimicrobial target: lack of affinity of the drug for the bacterial target
circumvent / find way around consequences of antimicrobial action: and accessibility of drug into the bacterial cell
uncouple antimicrobic-target interactions
Thus, antibiotics combat some mech:
*don’t mem, just know this is how antibiotic resistance is combated
Emergence of antimicrobial resistance:
Mixing of bac gene pool + selective pressure from excessive antimicrobial use and abuse =>survival of the fittest (ones that survive antibiotics)
Emergence of new genes
spread of old genes to new hosts
mutations of old genes resulting in more potent resistance
emergence of intrinsically resistant opportunistic bacteria


MIC assessment (microplate method): evaluate and interpret test results/meaning
Lowest concentration of antimicrobial agent capable of preventing growth of the microbe
tube and microplate methods
lowest concentration that gets desired outcome of drug
inhibition could be by a bactericidal or bacteriostatic mechanism
Shows MIC (lowest conc antibiotic that inhib growth) and checks validity of microplate with controls
Move to next test: (MBC) Streak MIC on agar plates to see if cidal or static mech (if no growth on plate cidal, if growth on plate that is just media then static bc antibi only inhibits growth)
eval and interpret Minimal bactericidal concentration (MBC) assessment
Lowest concentration of antimicrobial agent capable of killing the microbe
Performed by inoculating agar plates with bac from MIC microwells
If bacteria do not grow on plates once removed from antibiotic Ridge environment of MIC well, then antimicrobic agent has a kill effect
If bacteria do grow on plates once removed from antibiotic Rich environment of MIC well, then antimicrobic agent has the effect of growth inhibition

MIC and MBC use to determine bactericidal versus bacteriostatic effects: (parallel studies)
Bacteriocidal: MIC values are close to or the same as MBC
Bacteriostatic: MIC values are lower than MBC values→easier to prevent growth than kill
MIC and MBC parallel studies: MIC (lowest conc antibiotic that inhib growth) and checks validity of microplate with controls. Move to next test: (MBC) Streak on agar plates to see if cidal or static mech (if no growth on plate cidal, if growth on plate that is just media then static bc antibi only inhibits growth)
Serum bactericidal test (SBT):
2 things needed for test
dilution of serum from patient on antimicrobic regimen (only done on occasion when patient resistant/ allergic/ treatment unfunctional to test if antibiotic is even working) to determine treatment effectiveness in inhibiting/killing the bacterial isolate responsible for the patient’s infection
Need specific bacterial isolate from isolate (serum from patient)
Growth of isolated colonies of infectious agent from patient and serum from patient who is on antibiotic (bac + antibi)
Kirby Bauer disk diffusion assay:
Use of paper discs on agar plate that contains growth of bacteria to determine zones of inhibition/bacterial growth
Etest establishes what, and why might someone chose to do this test over others
Establishment of antimicrobic density gradient in agar plate format – Manual method of providing susceptibility results (MIC) with ease of test performance and costs similar to disk diffusion method

Describe the principle of disk diffusion and relate it to zones of inhibition
4 step method
role of national comittee on clinical labroatory services (NCCLS)
3 results and their meaning/ how this is determined
(Kirby Baur susceptibility test)
Method of determining bacterial sensitivity to a panel of antimicrobics
used today and tests several at a time
results are susceptible, resistant, intermediate
Method:
Standardized suspension of bacteria is swabbed over surface of a specific type of agar plate in a manner that results in lawn growth
we want bacteria all over surface
three-way streak to prevent isolated colony growth
known approximate number of bacteria/ density across all assay
Paper discs containing single concentrations of antibacterial agents are placed on inoculated surface
Filter disk: saturated with specific concentration of antimicrobial agent
conc=MIC which allows to see which antimic works best
Test multiple antibiotics on same disk
Antibiotic diffuse into agar in all directions evenly while bacteria is growing during incubation
plates are incubated
diameters and millimeters of zones of inhibition of bacteria growth are measured
bacteria grow until reach susceptible antibi
personalized med: specific to particular patient - E coli is from patient sample for example
National Committee on Clinical Laboratory services:
determine when an organism becomes resistant due to changes in concentration of MIC;
they constantly monitor and set interpretive standards
Results:
Diameters of zones of inhibition of bacterial growth are measured and recorded as S, R, I
S: sensitive, susceptible: microbial growth is inhibited at concentration safely attainable in the patient
R: resistant: microbial growth is present at concentrations above what is safely attainable in the patient
I: intermediate: microbial growth is present at concentrations above susceptible breakpoint but may be effective under some conditions
Chart to det. S/R/I results

State the principle of the Etest: describe its performance and use: interpret Etest results.
where eclipse intersects scale means what on e test strip
Manual method of providing susceptibility results (MIC) with ease of test performance and costs similar to disk diffusion method
Establishment of antimicrobic density gradient in agar plate format
Use of thin plastic test strips impregnated on the underside with concentration of gradient of specific antimicro
antimicrobic gradient after overnight incubation forms on agar around test strip and gives rise to epileptic area of inhibition
similar mechanism to disc diffusion test with three-way street, except use strips that have different concentrations of diff antibiotics
MIC is determined as where the growth Eclipse intersects the scale on the e-test strip
State the definition of antibiogram and define its use and importance.
Susceptibility testing importance:
Patient has an infectious process and physician needs to know the best choices of antibiotics to prescribe (may already be on antimicrobic if urgent case, this can be tweaked with susceptibility test results)
microbial resistance to antimicrobics is suspected–commonly isolated back bacteria tend to develop resistance
Epidemiology
Investigate and track spread of infectious agents through a population
antimicrobic resistance patterns can be a supportive identifying characteristic
testing new drugs
efficacy assessment of new drug is necessary to be put on market
Test types: disk diffusion (Kirby Baur), Etest, automated methods (microplate susceptibility results (MIC) obtained by use of special instrumentation and reagents, but costly; VITEK 2 system incubates and reads cards w/ diff biochem and antimicrobes which is suspended in microbe in question)
Antibiograms:
Monthly report in hospitals of every major organism
Composite report of antimicrobial susceptibility profiles of bac isolates from w/in a community or locale
Some bac have typical antibiograms
E. coli sensitivity patterns (resistant to some endemic in a location)
Trends of resistance in specific pops/locations are ID
Best assess first line of treatment when sensitivity results are not yet available
Track emerging resistance in the hospital/community

define MRSA.
origin
cephlasporin role (what gen it took to find antimic activity
2 types
resistance is due to what
localized infection meaning
“Methicillin-resistant S. aureus”
Cephalosporins and MRSA:
Took 5 generations to find beta-lactam antimicrobic w MRSA and VRSA activity (ceftaroline)
Last antibiotic in line bc possible side effects, but powerful
Only drug that works on MRSA so valuable
Origin:
Used to be thought of as health care associated MRSA, but now community associated CA-MRSA(skin, soft tissue, etc) → why gyms have desanitizing sprays
MDR=multi drug resistant (many drugs are in this cat)
10% s. Aureus isolates in US are susceptible to penicillin
Many strains while resistant to penicillin remains susceptible to penicillinase stable penicillin, such as oxacillin and methicillin
Strains that are resistant to Amoxicillin and methicillin are termed methicillin-resistant staph. Aureus (MRSA)
Now some are resistant to all beta-lactam agents, including cephalosporins and carbapenems
Types:
HA-MRSA= Isolates often are multiply resistant to other commonly used antimicrobic agents,
erythromycin, clindamycin, tetracycline
nosocomial infections of patients or visitors
CA-MRSA=Isolates are often resistant only to beta-lactin antimicrobics and erythromycin
since 1996, MRSA strains resistant to Vancomycin have been reported
not used as first line drug unless patient has resistance to organism due to low TI
Resistance:
Chromosomally mediated resistance via mechA gene
Localized infections:
Superficial
Inflammatory response is elicited; immune response
Describe the importance of MRSA.
why commonly transmitted
resistant to what antimic agents
Some people Harbor staph A in nasal cavity as part of normal flora, but can transmit to others (passive carrier)
Now some are resistant to all beta-lactam agents, including cephalosporins and carbapenems
Define VRE, describe its importance and identify major problems associated with it.
causitive agent
endocartitis vs UTI infections and bac
cidal or static needed
type of therapy needed (3, and 4th if none work)
"vancomycin-resistant enterococci"
Enterococcus bacteria:
Prefix means intestinal tract
Common pathogen of the urinary tract
UTIs are usually treatable with ampicillin or penicillin
Most common UTI causing gram pos bac (most common in general is E. coli, which is gram neg)
Causative agent of endocarditis (heart)
Requires bacteriocidal antimicrobic therapy
Synergistic effect (combo antimic treatment) of combo therapy is treatment of choice
Ampicillin or penicillin (vancomycin for penicillin-alergic patients)
Aminoglycosides such as gentamicin (usually resistant to aminoglucosides when they are administered alone)
Vancomycin-resistance in enterococcal endocarditis can be life threatening:
Problematic
Enterococci are highly resistant to antimicrobics thereby causing vancomycin to be the only treatment option
If the enterococcus is VRE, then resistance to vancomycin is present and no antimicrobics remain that are therapeutically effective for treatment
Generations of cephalosporins/ what is special about this family of beta-lacams/cidal or static/mech
1–against gram pos
2–against both gram pos and neg
3–greatly against gram neg, enhanced against b-lacamase producing gram pos
4–true broad spec
5–MRSA and VRSA beta lactam antimic
Largest and most diverse family
Bactericidal
Mimic structure of D-ala link in peptidoglycan and bind to active site of penicillin binding proteins
only treatment for MRSA and VRSA
treatment for TB patients
gen 5 cephalosporin—>some rez to this now too
rifampin
two drugs that cross bbb
sulfa drugs and chloramphenicol
ESBL bac tend to be gram pos or neg
neg